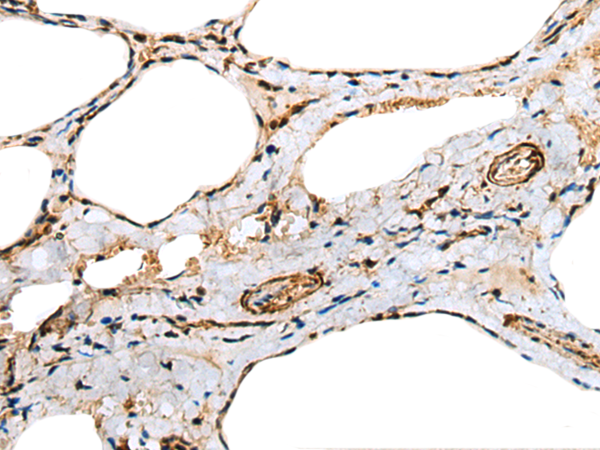
一抗

|
Background: |
Troponin is a central regulatory protein of striated muscle contraction, and together with tropomyosin, is located on the actin filament. Troponin consists of 3 subunits: TnI, which is the inhibitor of actomyosin ATPase; TnT, which contains the binding site for tropomyosin; and TnC, the protein encoded by this gene. The binding of calcium to TnC abolishes the inhibitory action of TnI, thus allowing the interaction of actin with myosin, the hydrolysis of ATP, and the generation of tension. |
|
Applications: |
ELISA, WB |
|
Name of antibody: |
TNNC1 |
|
Immunogen: |
Full length fusion protein |
|
Full name: |
troponin C type 1 (slow) |
|
Synonyms: |
TNC; TN-C; TNNC; CMD1Z; CMH13 |
|
SwissProt: |
P63316 |
|
ELISA Recommended dilution: |
5000-10000 |
|
WB Predicted band size: |
18 kDa |
|
WB Positive control: |
Mouse skeletal muscle tissue |
|
WB Recommended dilution: |
500-2000 |


 購物車
購物車 幫助
幫助
 021-54845833/15800441009
021-54845833/15800441009